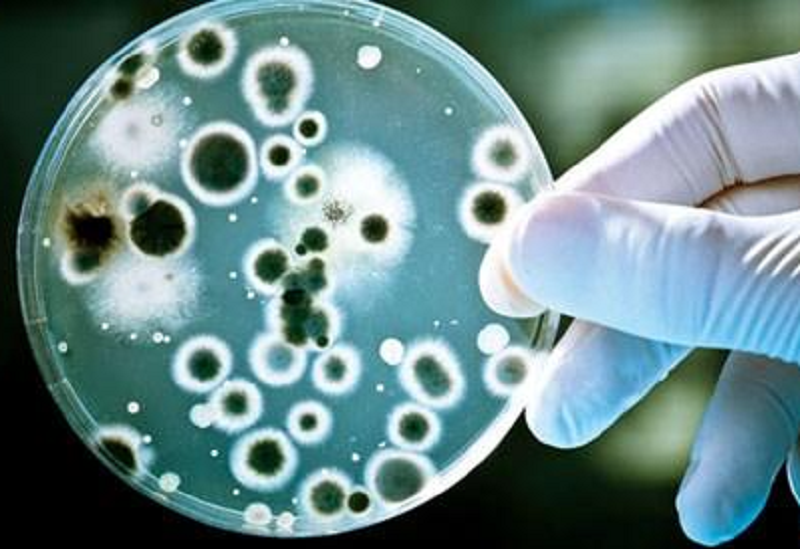
Vi khuẩn kháng thuốc đang là thách thức rất lớn đối với hoạt động điều trị cho người bệnh (ảnh minh họa) Vi khuẩn kháng thuốc đang là thách thức rất lớn đối với hoạt động điều trị cho người bệnh (ảnh minh họa)

Ngày 8/7, BS.Trần Thanh Nam – Khoa Hồi sức Tim mạch, Bệnh viện Nhân Dân Gia Định cho biết, trường hợp trên là bệnh nhân Đ.V.Y.N (21 tuổi, quê ở xã Thái Mỹ, TP.HCM), được đưa đến bệnh viện trong tình trạng sốt cao, đau hông và bụng.
Chẩn đoán ban đầu xác định bệnh nhân bị viêm thận – bể thận cấp cả hai bên, nhiễm trùng huyết và bệnh lý nền đái tháo đường mới được phát hiện. Dù được điều trị kháng sinh phổ rộng, tình trạng của người bệnh vẫn diễn tiến xấu rất nhanh với các biểu hiện sốt liên tục, lơ mơ, tụt huyết áp, suy hô hấp và suy đa cơ quan. Sau 48 giờ nhập viện, người bệnh rơi vào nguy kịch, bác sĩ phải hỗ trợ thở máy xâm lấn và lọc máu hấp phụ.
|
| Vi khuẩn kháng thuốc đang là thách thức rất lớn đối với hoạt động điều trị cho người bệnh (ảnh minh họa) |
Tuy nhiên, tình trạng bệnh vẫn tiếp tục diễn biến xấu, sau 5 ngày nhập viện, bệnh nhân bị tổn thương phổi lan sang hai bên, giảm oxy máu kháng trị (hội chứng nguy kịch hô hấp cấp - ARDS). Các bác sĩ đã thực hiện cấy máu cho người bệnh. Kết quả xác định tác nhân khiến cô gái trẻ rơi vào nguy kịch là do nhiễm vi khuẩn Klebsiella pneumoniae. Đây là loại vi khuẩn gram âm nguy hiểm với khả năng đề kháng cao, kháng hầu hết các loại kháng sinh mạnh hiện có. Người nhiễm vi khuẩn này nguy cơ tử vong rất cao nếu không kiểm soát sớm.
Trước diễn tiến nguy kịch, các bác sĩ quyết định sử dụng kỹ thuật oxy hóa máu qua màng ngoài cơ thể (ECMO), phương thức tĩnh – tĩnh mạch (V-V ECMO) để hỗ trợ hô hấp. Đây là lựa chọn cuối cùng khi phổi không còn khả năng trao đổi khí hiệu quả.
Theo BS.Trần Thanh Nam, đặt ECMO ở bệnh nhân béo phì luôn là một thách thức lớn vì mô mỡ dày, mạch máu nằm sâu và nguy cơ cao về đông máu, tắc mạch, nhiễm trùng. Nhưng nếu không can thiệp, người bệnh không thể qua khỏi. Nhờ phối hợp đa chuyên khoa, bệnh nhân được đặt ECMO thành công và điều trị tích cực theo phác đồ. Sau hơn 1 tuần điều trị, các bác sĩ đã thành công tiêu diệt tác nhân gây nhiễm trùng, giúp người bệnh qua nguy kịch.
 |
| Các bác sĩ đã kịp thời chẩn đoán, điều trị giúp nữ sinh viên vượt qua nguy kịch |
TS.BS.Giang Minh Nhật – Phó trưởng khoa Hồi sức Tim mạch cảnh báo, béo phì không chỉ gây tiểu đường, tăng huyết áp mà còn khiến cơ thể nhạy cảm với nhiễm trùng và khó kiểm soát khi đã mắc. “Vi khuẩn kháng thuốc như Klebsiella pneumoniae đang trở thành mối đe dọa lớn trong bệnh viện. Khi kết hợp với yếu tố nền như béo phì, nguy cơ tử vong sẽ tăng cao”.
Theo thống của ngành y tế, tỷ lệ người trưởng thành béo phì ở Việt Nam đang tăng nhanh, ước tính đã vượt mốc 20%. Các bác sĩ khuyến cáo, người được chẩn đoán thừa cân, béo phì nên khám định kỳ, theo dõi chuyển hóa và chủ động kiểm soát cân nặng. Khi có dấu hiệu sốt, đau bụng hoặc tiểu bất thường, cần đến bệnh viện sớm.


